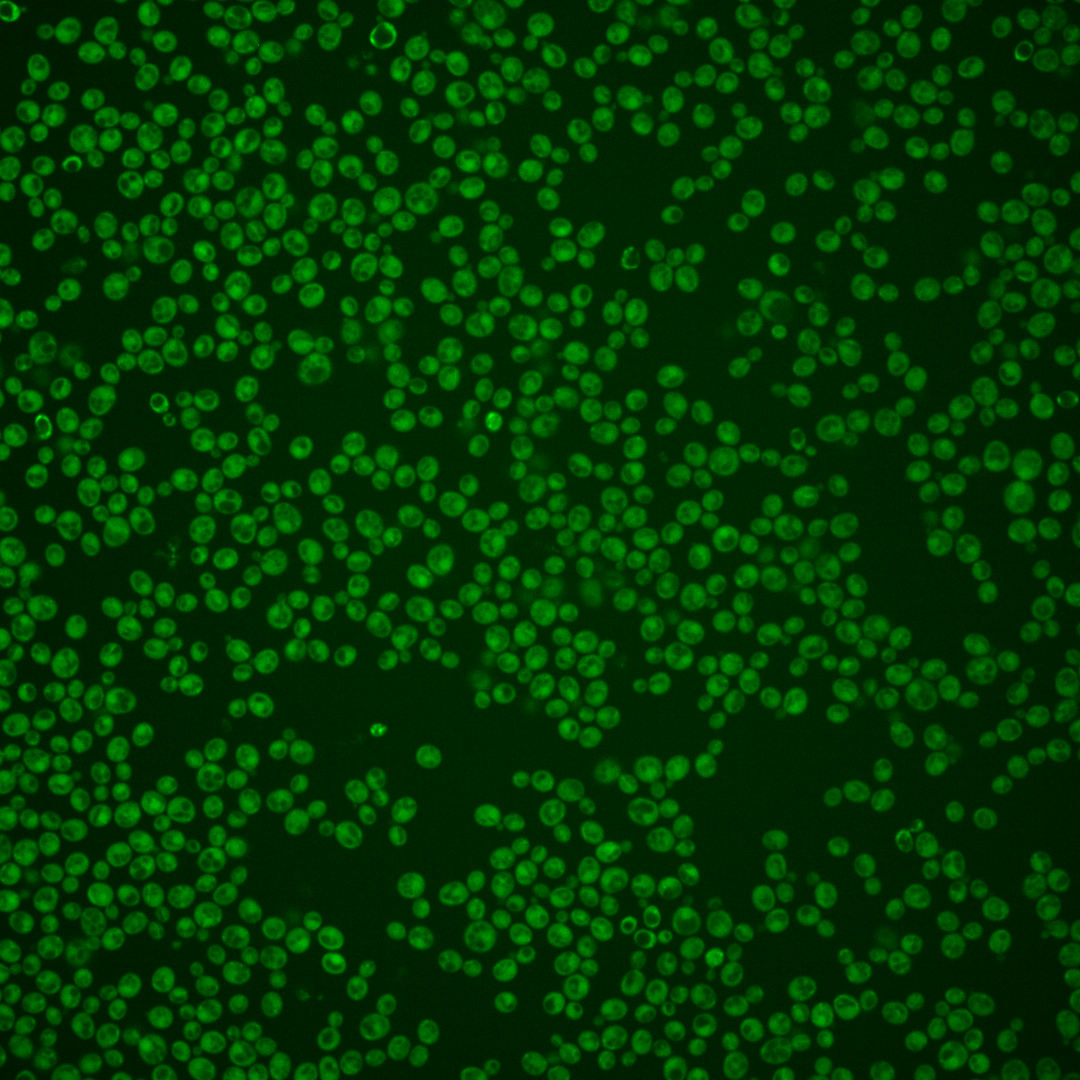
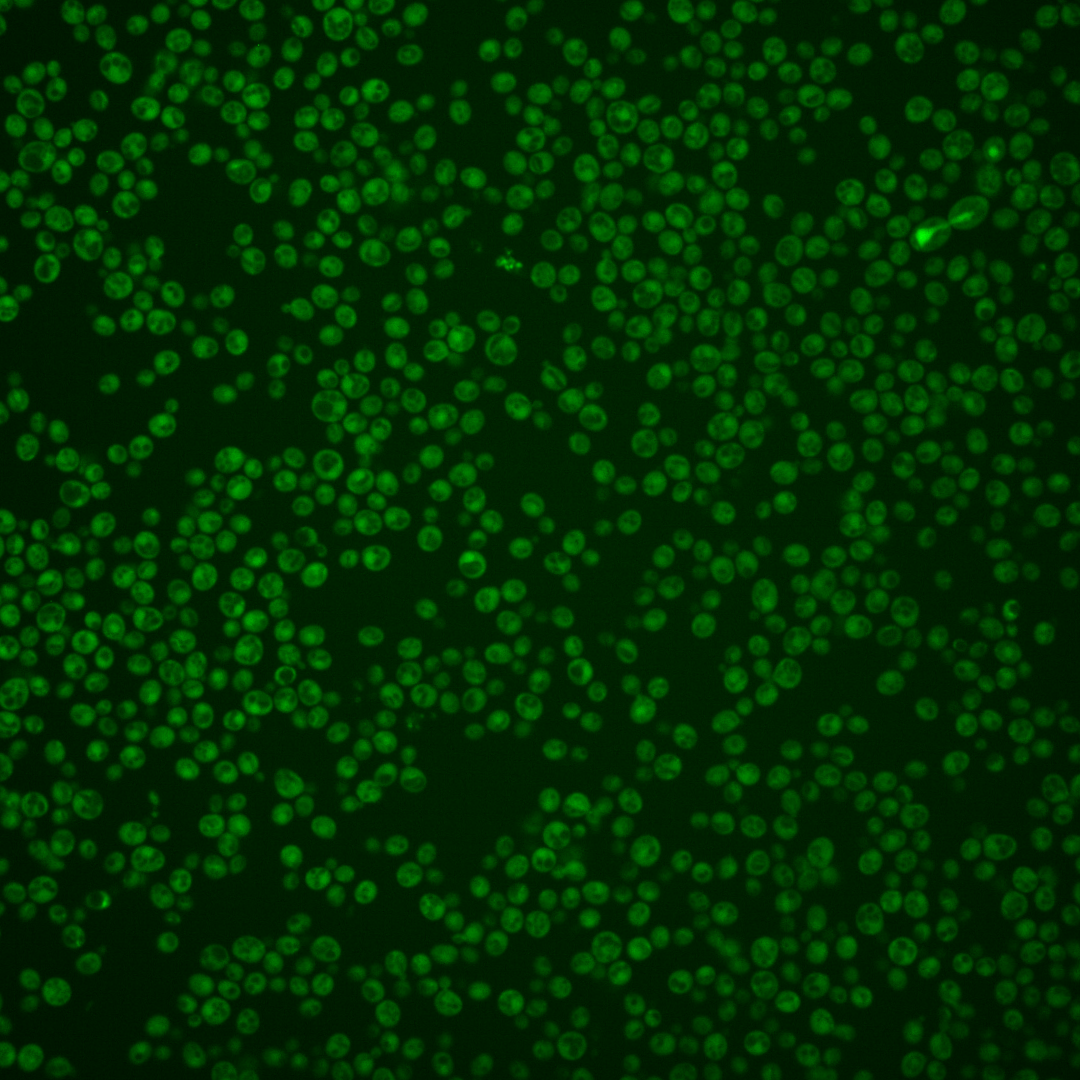
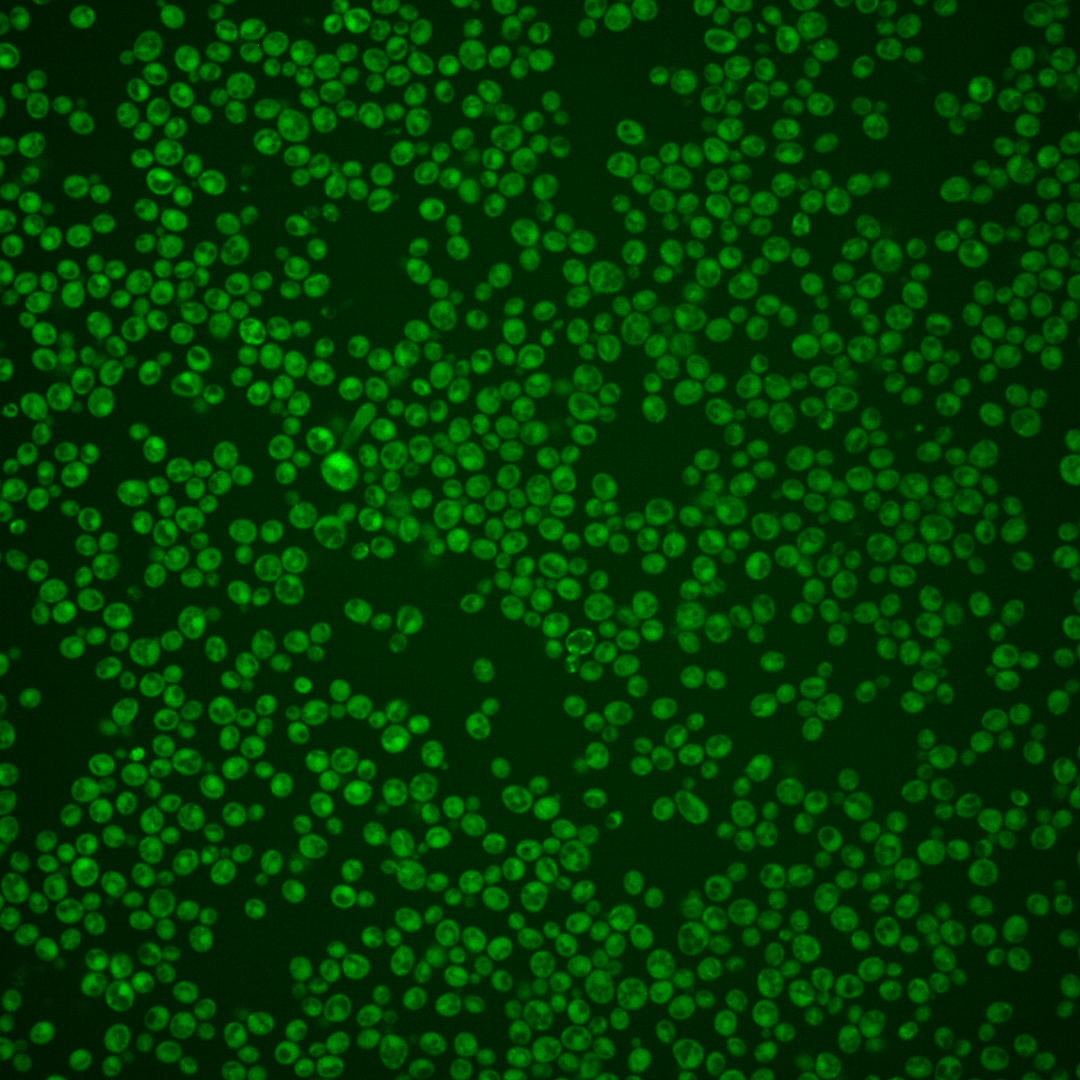
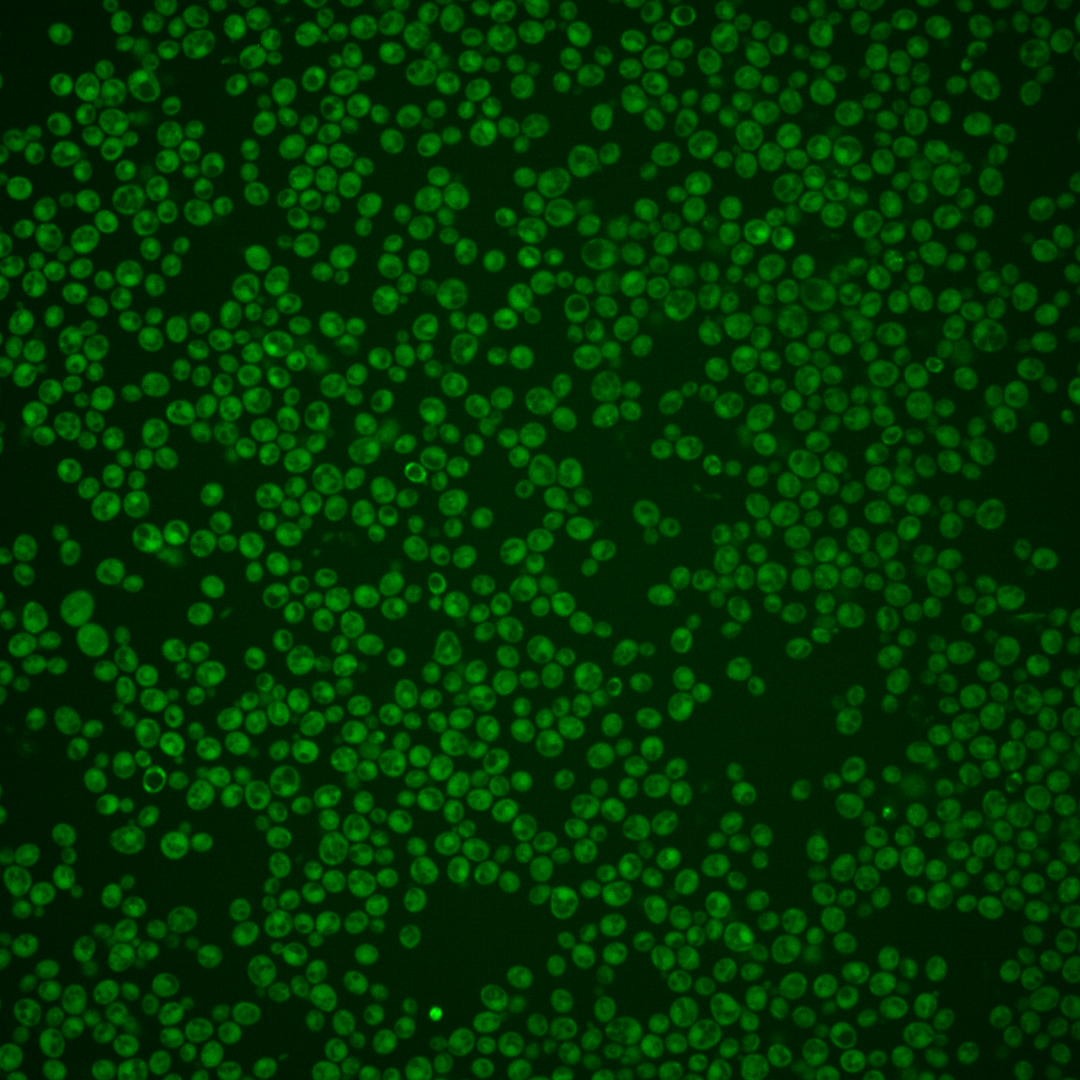

| Standard name | |
|---|---|
| Human Ortholog | |
| Description | GTPase-activating protein (GAP) for Cin4p; tubulin folding factor C involved in beta-tubulin (Tub2p) folding; mutants display increased chromosome loss and benomyl sensitivity; human homolog RP2 complements yeast null mutant |
Micrographs




















































































Sub-cellular Localization
Yeast GFP Assignment
Protein Abundance
Localization Change
External localization resources
| ensLOC | DeepLoc | |||||||||||||||||||||||
|---|---|---|---|---|---|---|---|---|---|---|---|---|---|---|---|---|---|---|---|---|---|---|---|---|
| Localization | WT1 | WT2 | WT3 | RAP60 | RAP140 | RAP220 | RAP300 | RAP380 | RAP460 | RAP540 | RAP620 | RAP700 | HU80 | HU120 | HU160 | rpd3Δ_1 | rpd3Δ_2 | rpd3Δ_3 | WT1 | WT2 | WT3 | AF100 | AF140 | AF180 |
| Cortical Patches | 0 | 1 | 1 | 3 | 3 | 2 | 1 | – | 1 | 2 | 5 | 3 | 0 | 1 | 0 | 0 | 1 | 0 | 0 | 0 | 3 | 3 | 3 | 3 |
| Bud | 0 | 3 | 0 | 0 | 2 | 1 | 1 | – | 4 | 4 | 8 | 7 | 1 | 1 | 0 | 0 | 0 | 0 | 0 | 0 | 1 | 1 | 3 | 4 |
| Bud Neck | 0 | 0 | 0 | 0 | 0 | 0 | 1 | – | 0 | 1 | 0 | 0 | 0 | 0 | 0 | 0 | 0 | 0 | 0 | 0 | 3 | 1 | 2 | 2 |
| Bud Site | 0 | 0 | 0 | 0 | 0 | 0 | 0 | – | 0 | 0 | 0 | 2 | 0 | 0 | 0 | 0 | 0 | 0 | – | – | – | – | – | – |
| Cell Periphery | 2 | 2 | 12 | 7 | 4 | 11 | 5 | – | 2 | 7 | 4 | 5 | 2 | 6 | 5 | 5 | 2 | 3 | 0 | 0 | 0 | 0 | 0 | 0 |
| Cytoplasm | 137 | 221 | 246 | 193 | 204 | 240 | 209 | – | 114 | 188 | 126 | 149 | 300 | 539 | 617 | 193 | 189 | 190 | 131 | 229 | 221 | 242 | 240 | 284 |
| Endoplasmic Reticulum | 0 | 1 | 2 | 3 | 5 | 8 | 9 | – | 2 | 1 | 0 | 6 | 1 | 4 | 1 | 5 | 7 | 9 | 0 | 0 | 4 | 1 | 1 | 3 |
| Endosome | 0 | 0 | 1 | 2 | 10 | 27 | 14 | – | 10 | 10 | 12 | 23 | 0 | 0 | 0 | 2 | 0 | 0 | 5 | 3 | 4 | 2 | 4 | 6 |
| Golgi | 0 | 0 | 0 | 0 | 1 | 0 | 0 | – | 0 | 0 | 0 | 0 | 0 | 0 | 0 | 0 | 1 | 1 | 0 | 1 | 1 | 0 | 1 | 0 |
| Mitochondria | 1 | 10 | 0 | 7 | 2 | 39 | 35 | – | 113 | 119 | 132 | 185 | 0 | 1 | 0 | 6 | 6 | 3 | 1 | 7 | 18 | 6 | 8 | 13 |
| Nucleus | 1 | 0 | 0 | 2 | 0 | 2 | 2 | – | 4 | 3 | 4 | 5 | 1 | 1 | 1 | 1 | 0 | 1 | 0 | 1 | 0 | 2 | 3 | 0 |
| Nuclear Periphery | 0 | 0 | 0 | 0 | 0 | 0 | 0 | – | 1 | 0 | 0 | 1 | 0 | 0 | 0 | 0 | 0 | 0 | 0 | 0 | 0 | 0 | 0 | 1 |
| Nucleolus | 1 | 0 | 1 | 0 | 0 | 0 | 0 | – | 0 | 0 | 0 | 1 | 0 | 0 | 0 | 0 | 0 | 0 | 0 | 0 | 0 | 0 | 1 | 0 |
| Peroxisomes | 0 | 0 | 0 | 0 | 0 | 1 | 0 | – | 0 | 0 | 0 | 0 | 0 | 0 | 0 | 0 | 0 | 0 | 0 | 0 | 0 | 0 | 0 | 0 |
| SpindlePole | 0 | 0 | 2 | 0 | 3 | 1 | 4 | – | 1 | 4 | 2 | 5 | 0 | 0 | 0 | 0 | 0 | 1 | 1 | 0 | 3 | 1 | 1 | 3 |
| Vac/Vac Membrane | 4 | 0 | 7 | 0 | 20 | 40 | 47 | – | 24 | 19 | 25 | 40 | 0 | 2 | 9 | 1 | 1 | 3 | 1 | 2 | 1 | 5 | 2 | 4 |
| Unique Cell Count | 141 | 230 | 260 | 202 | 237 | 336 | 303 | 233 | 303 | 262 | 358 | 301 | 548 | 619 | 198 | 194 | 195 | 147 | 251 | 272 | 273 | 280 | 341 | |
| Labelled Cell Count | 146 | 238 | 272 | 217 | 254 | 372 | 328 | 276 | 358 | 318 | 432 | 305 | 555 | 633 | 213 | 207 | 211 | 147 | 251 | 272 | 273 | 280 | 341 | |
Yeast GFP Assignment
Protein Abundance
| Screen | WT1 | WT2 | WT3 | RAP60 | RAP140 | RAP220 | RAP300 | RAP380 | RAP460 | RAP540 | RAP620 | RAP700 | HU80 | HU120 | HU160 | rpd3Δ_1 | rpd3Δ_2 | rpd3Δ_3 | AF100 | AF140 | AF180 |
|---|---|---|---|---|---|---|---|---|---|---|---|---|---|---|---|---|---|---|---|---|---|
| Mean Cell GFP Intensity (1e-4) | 6.4 | 5.1 | 7.1 | 7.0 | 7.6 | 6.2 | 6.1 | – | 5.2 | 5.3 | 5.3 | 5.2 | 6.6 | 6.4 | 6.3 | 5.4 | 6.4 | 6.4 | 7.3 | 7.3 | 7.0 |
| Std Deviation (1e-4) | 0.8 | 0.7 | 1.0 | 1.8 | 1.8 | 1.5 | 1.7 | – | 1.3 | 1.0 | 1.6 | 0.9 | 0.9 | 1.0 | 1.0 | 1.1 | 1.1 | 1.3 | 1.8 | 1.4 | 1.2 |
| Intensity Change (Log2) | – | – | – | -0.04 | 0.09 | -0.22 | -0.23 | – | -0.47 | -0.44 | -0.43 | -0.46 | -0.11 | -0.15 | -0.19 | -0.39 | -0.16 | -0.17 | 0.03 | 0.03 | -0.03 |
Localization Change
| Localization | RAP60 | RAP140 | RAP220 | RAP300 | RAP380 | RAP460 | RAP540 | RAP620 | RAP700 | HU80 | HU120 | HU160 | rpd3Δ_1 | rpd3Δ_2 | rpd3Δ_3 |
|---|---|---|---|---|---|---|---|---|---|---|---|---|---|---|---|
| Cortical Patches | 0 | 0 | 0 | 0 | – | 0 | 0 | 0 | 0 | 0 | 0 | 0 | 0 | 0 | 0 |
| Bud | 0 | 0 | 0 | 0 | – | 0 | 0 | 0 | 0 | 0 | 0 | 0 | 0 | 0 | 0 |
| Bud Neck | 0 | 0 | 0 | 0 | – | 0 | 0 | 0 | 0 | 0 | 0 | 0 | 0 | 0 | 0 |
| Bud Site | 0 | 0 | 0 | 0 | – | 0 | 0 | 0 | 0 | 0 | 0 | 0 | 0 | 0 | 0 |
| Cell Periphery | -0.6 | -1.8 | -0.8 | -2.0 | – | -2.5 | -1.5 | -2.0 | -2.4 | -3.0 | -3.2 | -3.7 | -1.2 | -2.2 | -1.8 |
| Cytoplasm | 0.5 | -3.2 | -7.2 | -7.7 | – | -11.4 | -9.2 | -11.7 | -13.5 | 3.7 | 3.0 | 5.1 | 1.5 | 1.5 | 1.5 |
| Endoplasmic Reticulum | 0 | 0 | 0 | 1.9 | – | 0 | 0 | 0 | 0 | 0 | 0 | 0 | 0 | 0 | 0 |
| Endosome | 0 | 2.9 | 4.4 | 3.1 | – | 2.9 | 2.5 | 3.1 | 3.8 | 0 | 0 | 0 | 0 | 0 | 0 |
| Golgi | 0 | 0 | 0 | 0 | – | 0 | 0 | 0 | 0 | 0 | 0 | 0 | 0 | 0 | 0 |
| Mitochondria | 0 | 0 | 5.7 | 5.7 | – | 12.8 | 11.4 | 13.2 | 13.8 | 0 | 0 | 0 | 0 | 0 | 0 |
| Nucleus | 0 | 0 | 0 | 0 | – | 0 | 0 | 0 | 0 | 0 | 0 | 0 | 0 | 0 | 0 |
| Nuclear Periphery | 0 | 0 | 0 | 0 | – | 0 | 0 | 0 | 0 | 0 | 0 | 0 | 0 | 0 | 0 |
| Nucleolus | 0 | 0 | 0 | 0 | – | 0 | 0 | 0 | 0 | 0 | 0 | 0 | 0 | 0 | 0 |
| Peroxisomes | 0 | 0 | 0 | 0 | – | 0 | 0 | 0 | 0 | 0 | 0 | 0 | 0 | 0 | 0 |
| SpindlePole | 0 | 0 | 0 | 0 | – | 0 | 0 | 0 | 0 | 0 | 0 | 0 | 0 | 0 | 0 |
| Vacuole | 0 | 2.8 | 4.1 | 5.1 | – | 3.5 | 2.0 | 3.3 | 3.9 | 0 | 0 | 0 | 0 | 0 | 0 |
External localization resources
Images






























Protein Concentration and Protein Localization Data
| R1 | R2 | R3 | ||||||||||||||||
|---|---|---|---|---|---|---|---|---|---|---|---|---|---|---|---|---|---|---|
| G1 Pre-START | G1 Post-START | S/G2 | Metaphase | Anaphase | Telophase | G1 Pre-START | G1 Post-START | S/G2 | Metaphase | Anaphase | Telophase | G1 Pre-START | G1 Post-START | S/G2 | Metaphase | Anaphase | Telophase | |
| Concentration | 6.1752 | 6.7615 | 6.677 | 6.0205 | 6.6394 | 6.3389 | 3.479 | 4.6568 | 4.5459 | 4.4204 | 3.5322 | 4.4189 | 0.9347 | 1.9367 | 1.6467 | 1.6167 | 1.1291 | 1.5531 |
| Actin | 0.0366 | 0.0014 | 0.0253 | 0.0295 | 0.0441 | 0.0032 | 0.0444 | 0.001 | 0.0165 | 0.0067 | 0.0012 | 0.0012 | 0.0967 | 0.0019 | 0.0534 | 0.0236 | 0.0067 | 0.008 |
| Bud | 0.002 | 0.0025 | 0.0017 | 0.0014 | 0.0005 | 0.0009 | 0.0003 | 0.0004 | 0.0005 | 0.0004 | 0.0002 | 0.0001 | 0.001 | 0.0005 | 0.0024 | 0.0003 | 0.0002 | 0.0001 |
| Bud Neck | 0.0046 | 0.0005 | 0.0077 | 0.0024 | 0.0012 | 0.0092 | 0.0014 | 0.0025 | 0.0008 | 0.0015 | 0.0007 | 0.0013 | 0.0164 | 0.0003 | 0.0018 | 0.0013 | 0.0008 | 0.0021 |
| Bud Periphery | 0.0027 | 0.0012 | 0.0015 | 0.0011 | 0.0007 | 0.0009 | 0.0003 | 0.0002 | 0.0005 | 0.0005 | 0.0002 | 0.0001 | 0.0016 | 0.0004 | 0.0021 | 0.0003 | 0.0002 | 0.0001 |
| Bud Site | 0.0111 | 0.0265 | 0.0051 | 0.0195 | 0.001 | 0.0005 | 0.0015 | 0.0307 | 0.0062 | 0.0016 | 0.0001 | 0.0002 | 0.0118 | 0.0034 | 0.0117 | 0.0004 | 0.0008 | 0.0002 |
| Cell Periphery | 0.0004 | 0.0005 | 0.0005 | 0.0005 | 0.0003 | 0.0002 | 0.0007 | 0.0007 | 0.0008 | 0.0003 | 0.0002 | 0.0001 | 0.0008 | 0.0003 | 0.0004 | 0.0001 | 0.0001 | 0 |
| Cytoplasm | 0.6308 | 0.8542 | 0.7733 | 0.8431 | 0.5144 | 0.821 | 0.4968 | 0.9024 | 0.8279 | 0.6868 | 0.9422 | 0.8998 | 0.6627 | 0.8815 | 0.7878 | 0.8566 | 0.6615 | 0.9275 |
| Cytoplasmic Foci | 0.0455 | 0.0139 | 0.0289 | 0.0284 | 0.0325 | 0.0155 | 0.0971 | 0.0078 | 0.0146 | 0.0188 | 0.0112 | 0.0136 | 0.0176 | 0.0118 | 0.0125 | 0.0067 | 0.0459 | 0.0236 |
| Eisosomes | 0.0003 | 0 | 0.0001 | 0.0002 | 0.0016 | 0 | 0.0002 | 0 | 0.0003 | 0.0002 | 0 | 0 | 0.0008 | 0 | 0.0003 | 0.0001 | 0.0001 | 0 |
| Endoplasmic Reticulum | 0.011 | 0.0029 | 0.0051 | 0.0022 | 0.0058 | 0.0024 | 0.0132 | 0.0024 | 0.0096 | 0.0066 | 0.0039 | 0.0061 | 0.0056 | 0.0038 | 0.0046 | 0.0031 | 0.0025 | 0.0034 |
| Endosome | 0.0338 | 0.0055 | 0.0114 | 0.0135 | 0.0841 | 0.0129 | 0.0376 | 0.001 | 0.0181 | 0.0161 | 0.0047 | 0.0194 | 0.0106 | 0.0096 | 0.0173 | 0.0041 | 0.0032 | 0.01 |
| Golgi | 0.0115 | 0.0009 | 0.005 | 0.0157 | 0.0508 | 0.0015 | 0.006 | 0.0005 | 0.0074 | 0.0041 | 0.0003 | 0.0014 | 0.0069 | 0.0015 | 0.0057 | 0.0028 | 0.0039 | 0.0025 |
| Lipid Particles | 0.0087 | 0.0001 | 0.0043 | 0.0007 | 0.0192 | 0.0033 | 0.0149 | 0.0002 | 0.0032 | 0.003 | 0.0001 | 0.0002 | 0.0101 | 0.0012 | 0.0095 | 0.0006 | 0.0418 | 0.0013 |
| Mitochondria | 0.0214 | 0.0005 | 0.0114 | 0.0052 | 0.0275 | 0.0046 | 0.0023 | 0.0001 | 0.0038 | 0.001 | 0.0001 | 0.0007 | 0.0091 | 0.0015 | 0.0061 | 0.0007 | 0.0022 | 0.0007 |
| None | 0.1254 | 0.0836 | 0.0928 | 0.0312 | 0.1558 | 0.1128 | 0.239 | 0.0444 | 0.0759 | 0.185 | 0.0314 | 0.0511 | 0.1131 | 0.0749 | 0.054 | 0.0954 | 0.1943 | 0.0146 |
| Nuclear Periphery | 0.0118 | 0.0005 | 0.0056 | 0.0006 | 0.007 | 0.0007 | 0.0022 | 0.0004 | 0.0032 | 0.0035 | 0.0008 | 0.0013 | 0.0057 | 0.0008 | 0.005 | 0.0007 | 0.0004 | 0.0004 |
| Nucleolus | 0.0003 | 0.0001 | 0.0008 | 0.0001 | 0.0023 | 0.0011 | 0.0022 | 0.0002 | 0.0002 | 0.0004 | 0 | 0 | 0.0007 | 0.0005 | 0.0002 | 0 | 0.0002 | 0 |
| Nucleus | 0.0049 | 0.0016 | 0.0043 | 0.0009 | 0.0044 | 0.0023 | 0.0026 | 0.0015 | 0.0017 | 0.055 | 0.0014 | 0.0012 | 0.002 | 0.0017 | 0.0023 | 0.0012 | 0.0007 | 0.0011 |
| Peroxisomes | 0.0234 | 0.001 | 0.0089 | 0.002 | 0.0315 | 0.0022 | 0.015 | 0.0001 | 0.003 | 0.0019 | 0.0001 | 0.0002 | 0.0211 | 0.0008 | 0.0192 | 0.0008 | 0.0315 | 0.003 |
| Punctate Nuclear | 0.0093 | 0.0005 | 0.0046 | 0.0004 | 0.0109 | 0.0012 | 0.0182 | 0.0021 | 0.0009 | 0.0051 | 0.0004 | 0.0004 | 0.003 | 0.0005 | 0.0013 | 0.0003 | 0.0027 | 0.0005 |
| Vacuole | 0.003 | 0.0019 | 0.0014 | 0.0011 | 0.0026 | 0.0026 | 0.0037 | 0.0011 | 0.0034 | 0.0012 | 0.0008 | 0.0013 | 0.002 | 0.0025 | 0.0018 | 0.0006 | 0.0003 | 0.0008 |
| Vacuole Periphery | 0.0015 | 0.0002 | 0.0004 | 0.0003 | 0.0018 | 0.0006 | 0.0004 | 0 | 0.0015 | 0.0003 | 0.0001 | 0.0004 | 0.0007 | 0.0005 | 0.0007 | 0.0001 | 0.0001 | 0.0001 |
Sequencing Data
| R1 | R2 | |||||||||
|---|---|---|---|---|---|---|---|---|---|---|
| G1 Post-START | S/G2 | Metaphase | Anaphase | Telophase | G1 Post-START | S/G2 | Metaphase | Anaphase | Telophase | |
| Gene Expression | 32.1314 | 13.445 | 3.6279 | 11.7926 | 26.5913 | 20.498 | 11.7405 | 12.5116 | 10.4496 | 28.3499 |
| Translational Efficiency | 1.2149 | 1.1626 | 1.7681 | 0.8441 | 1.2892 | 1.8307 | 1.1861 | 0.5059 | 0.8895 | 1.0238 |
Hit Data
| Dataset | Hit |
|---|---|
| Protein Concentration | ✔ |
| Protein Localization | ✘ |
| Gene Expression | ✔ |
| Translational Efficiency | ✘ |
Endocytosis
| Temp | Actin Patch (Sac6-tdTomato) | Cortical Patch (Sla1-GFP) | Late Endosome (Snf7-GFP) | Vacuole (Vph1-GFP) |
|---|---|---|---|---|
| 37℃ | ||||
| RT |
Cell Cycle Omics
CYCLoPs (Cin2-GFP)
| Gene / Allele | Actin Patch (Sac6-tdTomato) | Cortical Patch (Sla1-GFP) | Late Endosome (Snf7-GFP) | Vacuole (Sac6-tdTomato) |
|---|
| Gene | Images |
|---|
| Gene | Images |
|---|
Images are not yet available
Images are not yet available